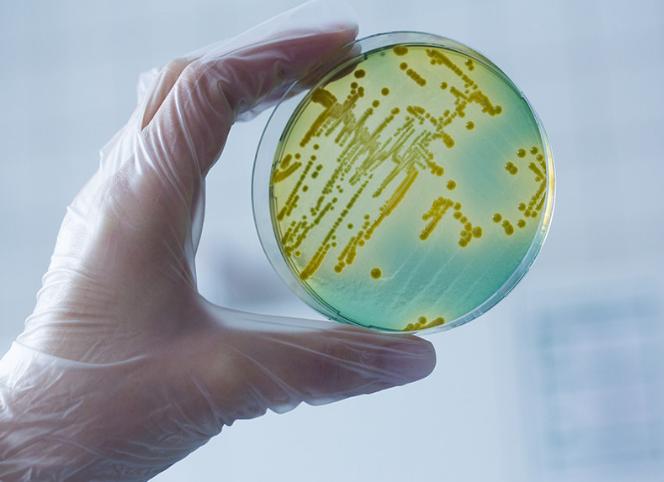
Бактериологическое исследование мочи

Бактериологическое исследование мочи
[Бактериологическое исследование мочи]
[Бактериологическое исследование мочи]
8. Бактериологическое исследование мочи
Оснащение:
— стерильная емкость объемом 250 мл с крышкой;
— направление.
Подготовка к процедуре:
— установите доверительные отношения с пациентом;
— объясните пациенту цель процедуры;
— обучите пациента проведению туалета наружных половых органов;
— оформите направление:
В бактериологическую лабораторию
направляется моча Иванова И.И., 30 лет
для определения микрофлоры и чувствительности к антибиотикам.
терапия 1
дата
подпись
— наклейте направление на емкость.
Выполнение процедуры:
— в 08.00 утра напомните пациенту тщательно подмыться и собрать в предложенную емкость 10-15 мл мочи из средней порции. Стерильная емкость должна оставаться открытой как можно меньше времени и не должна соприкасаться с нестерильными поверхностями.
Примечание. Для данного исследования собирать мочу лучше с помощью катетера.
Завершение процедуры:
— проконтролируйте, чтобы санитарка своевременно отнесла емкость с мочой в бактериологическую лабораторию.
9. Проба по Зимницкому
— 8 подписанных чистых емкостей объемом 250-500 мл;
— на приготовленные емкости наклейте направление, указав:
Проба по Зимницкому,
Иванов И.И., 30 лет.
Порция 1, 6-9ч.
терапия1
и так все 8 емкостей, последняя порция емкость – с 3 до 6 часов следующего утра.
— разбудите пациента в 06.00 утра, он должен опорожнить мочевой пузырь в унитаз и провести туалет наружных половых органов;
— напомните пациенту, что затем он должен каждые 3 часа опорожнять мочевой пузырь в соответствующую по времени емкость (6-9 часов, 9-12 часов, 12-15 часов, 15-18 часов, 18-21 час, 21-24 часа, 24-03 часа, 3-6 часов);
— ночью своевременно будите пациента.
— проконтролируйте, чтобы санитарка доставила все 8 емкостей в клиническую лабораторию.
Примечание. Эта проба предназначена для исследования функционального состояния почек. Она позволяет определить объем каждой порции, объем дневного и ночного диуреза, удельный вес мочи в каждой порции. Дневной диурез подсчитывают по 1-4 порциям, ночной – по 5-8 порциям. Дневной диурез должен быть в 2 раза больше ночного.
В норме удельный вес составляет 1012-1025. В утренней порции удельный вес относительно высокий (1018). Колебания удельного веса в отдельных порциях должны быть не менее 8-10, и хотя бы одна порция мочи должна иметь удельный вес 1012.
Одинаково низкий удельный вес во всех порциях мочи (гипоизостенурия) свидетельствует о нарушении концентрационной функции почек.
123. Основные методы исследования почек и мочевыводящих путей
1. Лабораторное исследование мочи.
2. Рентгенологическое исследование:
— обзорная рентгенография почек;
— томография;
— урография (пиелография). Может быть экскреторной, когда контрастное вещество водится внутривенно, и ретроградной (уретрография), когда контрастное вещество вводится в лоханку почки при помощи катетера.
Экскреторная урография
— шприцы одноразовые на 20 мл;
— рентгеноконтрастное вещество (урографин, верографин);
— все необходимое для постановки очистительной клизмы.
— объясните пациенту цель, ход предстоящего исследования и получите его согласие;
— за 3-4 дня до исследования назначается диета № 4 (бесшлаковая), в течение последующих 2-х дней исключаются из питания газообразующие продукты (овощи, фрукты, молочные продукты, черный хлеб, соки);
— при метеоризме пациенту назначается карболен;
— за 1-2 дня до исследования провести пробу на чувствительность к контрастному веществу одним из двух способов:
а) кожный – смазывают участок кожи на животе настойкой йода;
б) прием внутрь раствора йодистого калия по 1 ст. ложке 3 раза в день.
При отрицательной пробе продолжают подготовку.
— за 18-20 часов до исследования исключается прием пищи;
— вечером накануне исследования в 22.00 и утром за 2 часа до исследования сделайте пациенту очистительные клизмы;
— утром пациент не должен: есть, пить, курить, принимать лекарства;
— непосредственно перед исследованием опорожнить мочевой пузырь.
— провести пациента в палату.
Примечание: на рентгеноконтрастные средства могут быть побочные реакции, вплоть до коллапса и шока. Поэтому в рентгенкабинете всегда должны быть все необходимое для оказания экстренной помощи.
Бактериологическое исследование мочи
Бактериологическое исследование мочи направлено на определение возбудителя вызвавшего инфекцию в нижних мочевыводящих путях.
Получение образца мочи
Для бактериологического исследования нужна чистая средняя порция мочи. Важно, чтобы моча была получена до начала лечения антибиотиками, так как они быстро снижают количество бактерий, что может привести к искажению результата анализа.
Если больной уже принимает антибиотики, это необходимо указать в направлении.
Когда-то широко распространенная практика взятия мочи для микробиологических исследований путем катетеризации сегодня уже не актуальна, так как было обнаружено, что процесс катетеризации сам по себе связан с риском инфицирования.
Однако этот способ получения мочи для бакпосева применяется у пациентов с постоянным катетером. Любые бактерии, присутствующие в моче, будут быстро размножаться, оставаясь в дренажной сумке катетера. Поэтому мочу не следует брать из дренажной сумки, это приведет к неправильной оценке содержания бактерий в мочевом пузыре. Мочу следует собирать из изолированного рукава дренажной трубки, с помощью шприца и иглы, соблюдая асептику.
Асептика важна!
- снижает риск инфицирования пациента с катетером
- снижает риск перекрестного инфицирования персонала и других пациентов
- снижает риск загрязнения образца мочи бактериями из окружающей среды
Емкость для сбора мочи
Моча должна быть собрана в стерильную посуду.
Полностью заполнять емкость необязательно. Достаточно 5-10 мл.
Транспортировка в лабораторию
Моча является хорошей средой для роста бактерий. Любые бактерии, находящиеся в моче в момент ее сбора, будут продолжать размножаться в лабораторной посуде, что даст ложноположительный результат. Поэтому важно, чтобы моча была исследована не позднее, чем через несколько часов после ее сбора. Время взятия образца следует отметить в направлении.
Если отправка в лабораторию задерживается, мочу следует хранить в специальном холодильнике, так как низкая температура замедляет рост бактерий. Создан специальный метод, который позволяет провести посев мочи непосредственно после ее сбора. Пластинку, покрытую питательной средой, погружают в образец мочи, высушивают и отправляют в лабораторию.
В лаборатории
Как любой образец, предназначенный для микробиологического исследования, мочу необходимо:
- осмотреть макроскопически;
- исследовать под микроскопом;
- произвести посев на питательную среду, чтобы определить присутствие бактерий.
При обнаружении патогенных бактерий провести определение их чувствительности или устойчивости к ряду антибиотиков.
Макроскопический осмотр. Нормальная моча — прозрачная соломенно-желтая или желтая жидкость. Хотя по внешнему виду мочи невозможно поставить диагноз, наличие мочевой инфекции можно предположить. Как и другие бактериальные инфекции, инфекция мочевых путей связана с привлечением лейкоцитов для борьбы с бактериями. Мертвые и погибающие клетки, выделяющиеся из участка, пораженного инфекцией, в составе воспалительного экссудата, называются гноем. Гной в моче (пиурия) делает мочу мутной. Однако отсутствие мути не гарантирует отсутствия инфекции, а мутная моча необязательно означает инфицирование, так как имеются и другие причины помутнения мочи. Инфицирование некоторыми бактериями может придавать моче неприятный запах.
Микроскопическое исследование. Определенный объем мочи исследуют под микроскопом, главным образом для обнаружения в ней лейкоцитов и эритроцитов. В норме моча содержит немного лейкоцитов и эритроцитов, но значительное увеличение количества лейкоцитов является подтверждением инфекционного процесса. Однако большое количество лейкоцитов может быть в моче и при отсутствии бактерий. И наоборот, у некоторых пациентов с инфекцией мочевых путей нет большого количества лейкоцитов в моче.
Инфекция иногда связана с увеличением количества эритроцитов (гематурия), но существуют и другие причины увеличения количества эритроцитов (большей частью, заболевания почек). В моче могут быть видны эпителиальные клетки, слущивающиеся с поверхности нижних отделов мочевыводящих путей. Эпителиальные клетки, слущивающиеся с поверхности женских половых путей, иногда обнаруживаемые в моче, не имеют патологического значения и скорее свидетельствуют о том, что моча была собрана неправильно и поэтому может содержать бактерии из женского полового тракта. Если бактерии присутствуют в моче в большом количестве, они могут быть видны при микроскопическом исследовании.
Посев. Гарантированное подтверждение наличия или отсутствия бактерий и их идентификация возможны только в культуре мочи. Культура в данном контексте означает совокупность жизнеспособных бактерий, полученных из мочи. Определенный объем мочи помещают на плотную культуральную среду в чашку Петри. Культуральная среда содержит все компоненты, необходимые для роста бактерий. Затем чашку Петри закрывают и помещают в термостат при температуре +37°С (оптимальная температура для роста бактерий) и оставляют на 24 часа. Рост любых бактерий проявляется в виде образования колоний на поверхности плотной среды. Каждая колония содержит тысячи бактерий, произошедших от единственной клетки, находившейся в моче. Число колоний прямо отражает число микробных клеток в образце. Если моча была стерильна, колоний может не быть (питательная среда остается неизмененной).
Как было сказано раньше, моча в норме может содержать небольшое количество бактерий, происходящих из нижней трети уретры, так что только присутствия бактерий (бактериурии) недостаточно для диагноза инфекции мочевыводящих путей.
Термин «значительная бактериурия» впервые применили в 1956 г. Касс (Kass) и Финленд (Finland) для диагностики инфекции мочевого тракта. Они определили, что с некоторыми оговорками количество бактерий, превышающее 105 (100 000) в 1 мл мочи, позволяет поставить диагноз инфекции мочевого тракта. Хотя позднее было показано, что симптомы инфекции мочевых путей могут появляться при количестве бактерий меньше 103/мл и что у некоторых пациентов симптомы отсутствуют при количестве бактерий больше 105/мл, показатель Касса до сих пор широко применяется, и количество бактерий больше 105/мл остается критерием для диагностики инфекции мочевых путей. Подсчитывая количество колоний, выросших при посеве известного объема мочи, можно определить начальную концентрацию бактерий в образце мочи.
Каждая колония — результат деления единственной клетки, так что колонии являются чистыми (содержат только один вид бактерий). Макроскопический вид колоний специфичен для каждого вида бактерий, но для их полной идентификации необходимы дальнейшие исследования.
Хотя известно, что инфекцию мочевых путей вызывает несколько типов бактерий, наиболее часто возбудителем является Е. coli. Случаи смешанной инфекции встречаются редко, за исключением пациентов с постоянным катетером. Поэтому обнаружение многих видов бактерий, из которых ни один не доминирует, означает скорее всего, что моча была загрязнена бактериями из нижней трети уретры или из аногенитальной области. Другими словами, образец был неправильно собран. Чистый рост (рост одного вида бактерий) с количеством бактерий больше 105/мл мочи позволяет поставить диагноз инфекции мочевых путей.
Чувствительность. Результаты этого анализа сообщают о том, какие антибиотики следует назначить в случае конкретной бактериальной инфекции. Разумеется, этот тест не проводят, если результаты посева мочи были отрицательны или выявлено незначительное количество бактерий. Целью этого анализа является определение чувствительности или устойчивости микроорганизма, вызвавшего инфекцию, к ряду антибиотиков. Бактерии устойчивы к антибиотику, если он не вызывает их гибели в культуре. При назначении пациенту такой антибиотик будет неэффективным. И наоборот, бактерии, чувствительные к данному антибиотику, погибнут в организме больного при его назначении.
Этот тест проводят, пересевая колонии бактерий на культуральные среды, содержащие ряд антибиотиков. После инкубации среды осматривают. Если бактерии устойчивы к проверяемому антибиотику, рост колоний сохраняется и культуральная среда выглядит так, как будто антибиотик в нее не был добавлен. Если бактерии чувствительны к проверяемому антибиотику, тогда рост бактериальных колоний отсутствует, а культуральная среда выглядит так, как будто в нее не добавляли микроорганизмы.
Так как тест на чувствительность требует дополнительного времени выращивания бактериальных колоний, существует неизбежная отсрочка (до 24 часов) выдачи заключения. Если имеется подтверждение инфекции мочевых путей, полученное при микроскопии, то есть имеется большое количество лейкоцитов и бактерий, некоторые лаборатории проводят тест на чувствительность к антибиотикам в образце мочи, не дожидаясь роста бактерий в культуре.
Расшифровка результатов
- Чистый рост бактерий при их количестве, превышающем 105/мл, указывает на инфекцию мочевых путей. Увеличение количества лейкоцитов (больше 10 в мм3) позволяет предположить наличие инфекции.
- Чистый рост и количество бактерий от 103 до 105в 1 мл мочи указывает на то, что нельзя ни подтвердить, ни отвергнуть диагноз «инфекция мочевых путей». Повышенное количество лейкоцитов (больше 10 в 1 мм3 мочи) подтверждает наличие инфекции мочевых путей. Чем выше количество лейкоцитов, тем вероятнее наличие инфекции.
- Смешанный рост бактерий указывает на возможное загрязнение, особенно при наличии эпителиальных клеток. Однако смешанный рост может маскировать инфекцию мочевого тракта, вызванную одним видом бактерий, находящихся в смешанной культуре, особенно если количество бактерий больше 105 в 1 мл мочи. Тщательно собранный повторный образец может прояснить ситуацию. Нормальное количество лейкоцитов указывает на то, что инфекция, скорее всего, отсутствует, тогда как большое количество лейкоцитов свидетельствует в пользу ее наличия.
- Стерильная моча или концентрация бактерий менее 103/мл указывает на отсутствие инфекции. Количество лейкоцитов меньше 10 в 1 мл мочи (при микроскопии) также указывает на отсутствие инфекции.
Бактериологическое исследование мочи was last modified: Декабрь 11th, 2017 by Мария Салецкая
Анализ мочи на посев
Бактериологический анализ мочи — один из точных лабораторных исследований качества урины. Назначается бак посев мочи в разных ситуациях: от выявления инфекций до определения чувствительности бактерий к антибактериальным препаратам. Повышенные требования к сбору материала на анализ и длительность теста — существенные недостатки, но в результате врач получает точные данные, которые не покажет другое лабораторное исследование.
Анализ на бактериологический посев: что показывает?
Посев мочи сдается для определения на бактериурию в мочеиспускательных органах человека — выявляет количество бактерий и чувствительность к лекарственному веществу. Исследование проводится при соблюдении медицинских норм и стандартов СЭС (санитарно-эпидемиологической станции). Положительным считают тот бактериологический посев мочи, где допустимая норма бактерий превышает естественный показатель. Тогда стоит задуматься о серьезных проблемах.
Анализ показывает вид микроорганизмов и их количество в материале взятом на исследование.
Урина по природе нестерильна, поэтому в нормальных условиях там будет минимальный процент стрептококков, стафилококков и дифтероидов. Лаборанты изучают концентрацию микробов в выделениях, после чего ставят оценку о состоянии работы органов (в частности, мочеполовых), и устанавливают, к каким лекарственным препаратам микробы чувствительны. Информация поможет врачу прописать эффективную терапию.
Нарушенная микрофлора бывает истинная и ложная. Истинная микрофлора выявит размножение бактерий в органах выделения. Тогда как ложная покажет, что микроорганизмы в урине попадают через кровоток из мест воспаления. Получается, анализ мочи на бак посев выявляет и диагностирует болезнь на ранней стадии.
Вернуться к оглавлению
Показания к назначению анализа
Золотистый стафилококк вызывает гнойные воспалительные процессы, что особо опасно при беременности.
Бактериологическое исследование мочи — обследование, о котором говорят редко, ведь чаще пациенты привыкли слышать об общем анализе мочи. Преимущество посева мочи — достоверность. Назначают такой тип анализа медицинские работники — урологи, гинекологи, нефрологи — при подозрении, что проблема вызвана инфекцией.
Анализ мочи на микрофлору, при помощи которого определяют чувствительность бактерий к группе антибиотиков, делают в случае:
- проверки, насколько эффективно проходит лечение;
- подозрения на инфекцию выделительных органов (сюда относят воспаление мочевого пузыря, почек, аномалия почек, мочекаменные болезни);
- уточнения или подтверждения диагноза;
- пониженного иммунитета;
- подозрения на сахарный диабет и туберкулез.
Бак посев мочи показывает возбудителя инфекции:
- Стафилококк. Стафилококк в моче опасен беременным женщинам.
- Хламидии. Бактерии в моче подтверждают сомнительные медицинские заключения.
- Гонорею. Назначают пациентам, партнеры которых могут быть носителями вируса.
- Бациллу Коха (БК или второе название ВК). Анализ на степень бактериурии определяет наличие туберкулеза.
- Bordetella pertussis, вызывающая коклюш. Сдача на бактериологический посев поможет выявить болезнь на ранней стадии, при начальных симптомах.
- Энтерококк и дизентерия. Взятие мочи назначают при заболеваниях органов ЖКТ у детей и взрослых.
Вернуться к оглавлению
Показания к назначению у женщин, мужчин и детей
При первых подозрениях на нарушение работы почек нужно сдать мочу на анализ.
Анализ мочи на посев чаще назначают беременным женщинам. Однако при болезненном мочеиспускании, боли в области поясницы первым делом женщина будет сдавать мочу на анализ. Ведь даже цистит, который не вызывает опасений, при неправильном лечении способен перерастать в воспаление почек. Сдавать анализ на бак посев пациентка должна только после менструации. Запрещено накануне анализа пользоваться свечами и спринцеваться.
У мужчин данный анализ берется не реже чем у женской половины населения. Причем направить может уролог, также терапевт. Мужская урина более насыщенна бактериями, так как при мочеиспускании стафилококки могут попасть из передней части уретры. Перед тем как собрать мочу на посев мужчинам советуют проводить подмывание половых органов перед мочеиспусканием.
Микробиологическое исследование мочи на флору у детей (и грудничков) назначает детский отоларинголог, гастроэнтеролог или другой врач. Помимо бак посева, сдается посев крови, анализ кала, мазки из носа или горла. Для исследования советуют брать утреннюю порцию, у грудничка — любую, какую возможно собрать. Как и у взрослых, детям нежелательно принимать лекарства накануне сдачи анализа. Показанием к назначению исследования у ребенка считают:
- повышенную температуру;
- подозрение на инфекцию;
- заболевание почек или мочевого пузыря.
Вернуться к оглавлению
5 требований к правильному сбору анализа
Соблюдая все правила сбора мочи для анализа можно получить достоверный результат.
Цель проведения анализа — показать реальную картину состояния внутренней флоры. Для этого стоит правильно подготовиться к мероприятию. Для достоверного результата врачи рекомендуют придерживаться следующих требований:
- Приготовить стерильную сухую емкость, чтобы туда не попали чужеродные микроорганизмы еще до забора мочи. В качестве такой емкости подойдет пластиковый контейнер для мочи с крышкой (продается в аптеке). Перед использованием лучше обдать кипятком.
- Накануне сдачи анализа не употреблять в пищу красящие овощи: морковь, свеклу.
- Не принимать мочегонные средства, антибактериальные препараты.
- Снизить физические нагрузки, которые влияют на состав урины.
- Избегать половой близости (за 24 часа до сдачи).
Вернуться к оглавлению
Как сдавать мочу на бак посев?
Общие рекомендации помогут избежать ошибок, которые совершают люди. Ошибки приводят к недостоверному результату, и придется сдавать анализ повторно. Но при четком выполнении, информация из лаборатории придет правдивой. Итак, делать забор мочи с вечера и хранить в холодильнике запрещено. Если температура в комнате составляет 20 градусов — подать урину на обследование нужно через 2 часа. В том случае, когда биоматериал храниться в холодильнике — сдается на анализ в течение 6-ти часов.
Собрать нужно утреннюю урину в стерильную емкость, чтобы предотвратить искажение результатов.
Количество материала для исследования неоднозначно. Одни источники говорят, что требуется 70 мл, а другие говорят, что 5 мл достаточно. Как бы там ни было, данный вопрос лучше уточнить у лечащего врача. Если пациента отправляют сдавать общий анализ мочи в СЭС, лучше поинтересоваться правилами приема материала в лаборатории (чтобы результат анализов был правдоподобным).
Вернуться к оглавлению
Подготовка и забор материала на анализ
Разобьем данный процесс на подготовительный этап и забор мочи. Подготовительный этап включает следующий алгоритм:
- перед сдачей не следует употреблять много жидкости, чтобы не снизить количество бактерий в выделениях;
- не опорожняться на протяжении 2-х часов;
- перед анализом, женщинам запрещено спринцевание;
- промыть наружные половые органы.
Как стоит готовиться ко второму этапу? Этот этап предусматривает:
- Для обследования подходит исключительно утренняя урина.
- Взять нужно среднюю порцию: для этого пропускают первую и конечную струю.
- Урину берут несколько дней подряд при подозрении на туберкулез.
- Использовать стерильные перчатки.
- Быстро доставить материал в лабораторию.
Правила для сбора мочи у детей аналогичны со взрослыми.
Вернуться к оглавлению
Как долго готовится результат?
Сколько дней делается анализ мочи на бактериальный посев? В любом случае, точный срок укажет работник лаборатории. Если результат анализа нужен в короткие сроки, то лучше его заранее сдать. Биоматериал из контейнера помещают в пробирку, где создается специальная среда для размножения и роста микробов. Проба оставляется на 5 дней. Получается, подождать придется от 7-ми до 10-ти дней.
Вернуться к оглавлению
Расшифровка бак посева: норма и нарушения
Спустя определенное время, придет результат микробиологического исследования мочи. Расшифровывать его совсем не сложно. В бумаге будут указаны виды грибов и бактерий, их количество и группа препаратов, которые справляются с ними. Чтобы расшифровать посев, требуется разобраться в терминах. В полученной бумаге с результатами будет присутствовать аббревиатура КОЕ. КОЕ значит «колониеобразующая единица». Если рост данной единицы не превышает 1000 КОЕ на мл, тогда лечение не потребуется, поскольку бактерии находятся в пределах нормы. Если показатель превышает миллион частиц — плохой результат. Это признак инфекции, которая вызывает воспалительный процесс. Если количество бактерий в моче немного превышает норму, у человека, как правило, в скором времени выявляют неприятную симптоматику: боль внизу живота и кровь в моче.
Бактериологическое исследование мочи
Бактериологическое исследование мочи направлено на определение возбудителя вызвавшего заболевание.
Получение образца мочи для бактериологического посева
Требуется чистая средняя порция мочи. Важно, чтобы образец был получен до начала лечения антибиотиками, так как они быстро снижают количество бактерий, что может привести к искажению результата анализа.
Когда-то широко распространенная практика взятия мочи для микробиологических исследований путем катетеризации была оставлена, так как было обнаружено, что процесс катетеризации сам по себе связан с риском инфицирования.
Однако этот способ применяется у пациентов с постоянным катетером. Любые бактерии, присутствующие в моче, будут быстро размножаться, оставаясь в дренажной сумке катетера. Поэтому мочу не следует брать из дренажной сумки, это приведет к неправильной оценке содержания бактерий в мочевом пузыре. Мочу следует собирать из изолированного рукава дренажной трубки, с помощью шприца и иглы, соблюдая асептику.
Асептика важна по следующим причинам:
■ это снижает риск инфицирования пациента с катетером;
■ это снижает риск перекрестного инфицирования персонала и других пациентов;
■ это снижает риск загрязнения образца мочи бактериями из окружающей среды.
Емкость для сбора мочи
Моча должна быть собрана в стерильную посуду. Полностью заполнять емкость необязательно. Достаточно 5-10 мл.
■ осмотреть макроскопически;
■ исследовать под микроскопом;
■ произвести посев на питательную среду, чтобы определить присутствие бактерий.
■ Чистый рост бактерий при их количестве, превышающем 105/мл, указывает на инфекцию мочевых путей. Увеличение количества лейкоцитов (больше 10 в мм3) позволяет предположить наличие инфекции.
■ Чистый рост и количество бактерий от 103 до 105в 1 мл мочи указывает на то, что нельзя ни подтвердить, ни отвергнуть диагноз «инфекция мочевых путей». Повышенное количество лейкоцитов (больше 10 в 1 мм3 мочи) подтверждает наличие инфекции мочевых путей. Чем выше количество лейкоцитов, тем вероятнее наличие инфекции.
■ Смешанный рост бактерий указывает на возможное загрязнение, особенно при наличии эпителиальных клеток. Однако смешанный рост может маскировать инфекцию мочевого тракта, вызванную одним видом бактерий, находящихся в смешанной культуре, особенно если количество бактерий больше 105 в 1 мл мочи. Тщательно собранный повторный образец может прояснить ситуацию. Нормальное количество лейкоцитов указывает на то, что инфекция, скорее всего, отсутствует, тогда как большое количество лейкоцитов свидетельствует в пользу ее наличия.
■ Стерильная моча или концентрация бактерий менее 103/мл указывает на отсутствие инфекции. Количество лейкоцитов меньше 10 в 1 мл мочи (при микроскопии) также указывает на отсутствие инфекции.












Комментарии 0